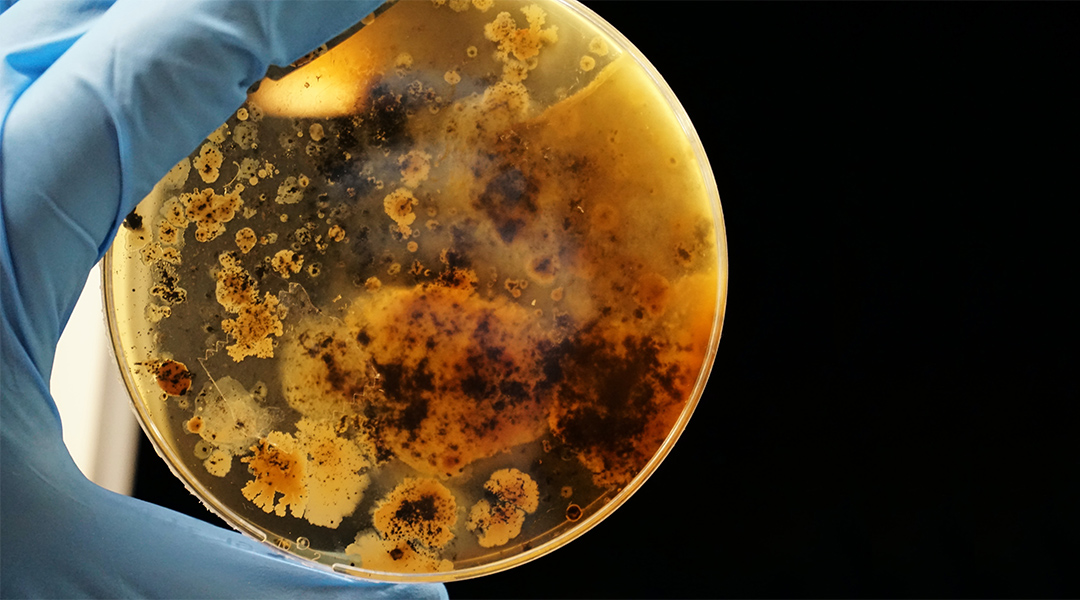

Using microrobots to eradicate bacteria
11. May 2021
Share via Facebook Share via Twitter
Article by by Lucie Bradley (May 7, 2021)
A team of scientists have created a cost-effective way to destroy bacterial biofilms, paving the way for advancements in everything from healthcare to utilities.
Biofilms are prolific and problematic. They cause large economic losses, from the failure of medical implants to enhanced erosion of pipes in our cities. However, scientists have devised a low-cost method to “clean up” biofilms, which could save society money, lives, and resources.
What are biofilms?
Biofilms are colonies of microorganisms, which can include algae, bacteria, and protozoa. These multicellular communities produce a glue-like substance to stick themselves — often in a matter of minutes — to a surface at a solid-liquid interface. Bacterial biofilms are particularly challenging. The bacteria cover themselves with protective mucus and are more resistant to disinfectants and antibiotics. “These have profound negative impact,” said Professor Martin Pumera, principal investigator for the study. In medicine, biofilms are frequently found on medical implants, teeth, catheters, and other surfaces, increasing the risk of infection or failure of the implant. They can also corrode water pipelines and contaminate the water — affecting taste, odor, color, and safety. “They cause about 100 billion USD annual loss just in USA,” said Pumera. Therefore, a robust method to effectively remove bacterial biofilms would be exceedingly valuable.
Biofilm-fighting microrobots
Micromotors — and their smaller counterparts, nanomotors — are synthetic objects that are autonomously self-propelled by using energy from their environment. Motion is facilitated by asymmetric structures, such as microjet engines or helix swimmers. The symmetry of the molecule breaks when the appropriate stimulus, such as a chemical fuel, is applied. This produces a gradient (electrical, chemical concentration, surface tension, or temperature) or the formation of bubbles, which in turn propels the motors. Few studies to date have considered using micromotors to deal with biofilms, and most existing micromotors are short-lived and expensive to create.
However, Pumera and colleagues synthesized micromotors made of zinc oxide doped with silver (ZnO:Ag) — both of which have antibacterial properties — using a relatively low-cost and environmentally benign method. The micromotors were stable, round-shaped stars (a rough ball covered with protruding microrods) that self-propel under UV light.
In laboratory tests, these micromotors killed more than 80% of the tested biofilms within 5 minutes. In particular, the bacteria Pseudomonas aeruginosa, which is often found in wounds and drinking water pipes, was killed with a very small amount of motors (1 μg mL−1) in a short time. In addition to causing cell death, the motors caused damage that hindered the formation of new biofilm.
These results create opportunities for the broad application of micromotors in biofilm removal in healthcare, industry, and environmental fields.
“We are now focusing on medical application of micro and nanorobotics in removal biofilms in medicine,” said Pumera. “We are also working on collective behavior of these motors, so they can act together and in coordinated action attack the bacteria.”
Reference: M. Ussia, et al., Active Light‐Powered Antibiofilm ZnO Micromotors with Chemically Programmable Properties, Advanced Functional Materials (2021). DOI: 10.1002/adfm.202101178
Source: Advanced Science News (překlad Kateřina Vlková)
Read More
12. Jan. 2021
Martin Pumera Among the Most Cited Scientists in the World
Last year, a group of authors associated with PLoS Biology, Elsevier and Stanford University published a list of 2% of the world's most cited…
28. Dec. 2020
Martin Pumera pro Forbes: Česko je nano. Patříme mezi země, které jsou s vývojem nejdál
Kompletní rozhovor s profesorem Pumerou si můžete přečíst ve speciálu Forbes NEXT, který je součástí prosincového vydání Forbesu. Ten film…
3. June 2019
You Just Need to Stop and Look Around Yourself, says Martin Pumera. the New Research Group Leader at CEITEC
Renowned expert and one of the most cited chemists in the world Martin Pumera newly leads CEITEC BUT research group called Future Energy and…


